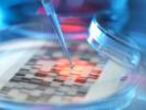

Un campo de refugiados junto a la milla de oro
Expatriados, activistas y vecinos plantan una réplica de un campamento en el centro de A Coruña para combatir el olvido y la desinformación


Una chaqueta roja abrochó las vidas del sirio Ahmad y la coruñesa Leticia en el campo de refugiados de Idomeni (Grecia). Una voluntaria alemana, compañera de la gallega, perdió la prenda con su pasaporte dentro en un campamento de 13.000 expatriados donde ese documento es un lingote de oro. Ambas acudieron al muchacho árabe para que les ayudara en la búsqueda y entonces se obró el milagro. La mujer que encontró la rebeca no solo se la devolvió recién lavada sino que les entregó el pasaporte.
“Aquella refugiada podía haberlo vendido en el mercado negro o falsificado”, resalta un año después Leticia, psicóloga y cooperante internacional de 28 años. Desde Idomeni, Ahmad logró llegar a A Coruña, donde intenta ahora reconstruir su existencia alejado de la barbarie. Los dos son voluntarios del proyecto Acampa, por la paz y el derecho a refugio, que desde este jueves y hasta el domingo, con la participación de 41 entidades, ha levantado un campo de refugiados en pleno centro de la ciudad, cerca de la milla de oro donde tienen casa potentados como Amancio Ortega y a pocos metros del puerto desde el se despedían los emigrantes gallegos que huyeron a América del hambre y la guerra.

Rodeados de una alambrada, activistas de ONG, sindicalistas, vecinos y militantes de partidos a los que no se ha unido el PP han plantado decenas de tiendas en los jardines de Méndez Núñez para recordar a quien les quiera escuchar la crisis humanitaria que sufren millones de personas a las puertas de Europa. El campamento simbólico acogerá un amplio programa de conciertos, coloquios y exposiciones artísticas, un esfuerzo de “contrainformación” para que la ciudadanía supere los “estigmas” que ciertos políticos y medios imponen a los refugiados y tenga presentes los compromisos incumplidos. El Gobierno español pactó dar cobijo a más de 17.000 desplazados pero, como recuerda Acampa en una gran pancarta, apenas faltan cien días para que el plazo expire y solo se han acogido 1.300.
Quienes han estado allí afirman que en los campos de refugiados siempre hay una rayuela. La que se extiende en el centro del campamento de A Coruña da entrada a la zona infantil, donde millones de niños refugiados juegan y estudian. Los ciudadanos que abrieron este jueves las visitas guiadas al recinto se sientan sobre los tablones de madera que sirven de pupitres y tocan la hilera de cajas de lata colgantes que igual hacen de canasta para lanzar piedras que de instrumento musical. La guía les enseña los barreños de aseo y lavado de ropa, la tienda con los desvencijados colchones en la que duermen los refugiados, el puesto para comprar o recibir comida y el dingui, la balsa en la que se lanzan a un viaje de vida o muerte más seguro que permanecer en tierra.
Chus, alumna de la Universidad Senior de A Coruña, escribe un mensaje y lo pega en los plásticos que se usan de pared: “Hay sitio para todos. Nosotros fuimos acogidos en otros tiempos. ¡Solidaridad!”. Primero confiesa que a la reproducción del campamento le falta algo para “impactar” y estar a la altura del sufrimiento real de sus habitantes, pero poco después confiesa que algo “le revuelve”. “Acampa nace como herramienta de cohesión, porque atomizados en cientos de iniciativas dispersas somos menos efectivos para defender los derechos humanos”, explica el fotógrafo Xosé Abad, miembro de la plataforma organizadora, que pretende que A Coruña sea solo primera ciudad española en impulsar una iniciativa similar.
Tras la historia de la chaqueta roja, Ahmad y Leticia luchan ahora por superar el laberinto de burocracia impuesto en España a los refugiados. Él ha decidido buscar su futuro al margen del programa para expatriados que le obligaba a mudarse a Barcelona. No está dispuesto a sufrir otro desplazamiento forzoso.
Síguenos en Twitter y en Flipboard
Tu suscripción se está usando en otro dispositivo
¿Quieres añadir otro usuario a tu suscripción?
Si continúas leyendo en este dispositivo, no se podrá leer en el otro.
FlechaTu suscripción se está usando en otro dispositivo y solo puedes acceder a EL PAÍS desde un dispositivo a la vez.
Si quieres compartir tu cuenta, cambia tu suscripción a la modalidad Premium, así podrás añadir otro usuario. Cada uno accederá con su propia cuenta de email, lo que os permitirá personalizar vuestra experiencia en EL PAÍS.
¿Tienes una suscripción de empresa? Accede aquí para contratar más cuentas.
En el caso de no saber quién está usando tu cuenta, te recomendamos cambiar tu contraseña aquí.
Si decides continuar compartiendo tu cuenta, este mensaje se mostrará en tu dispositivo y en el de la otra persona que está usando tu cuenta de forma indefinida, afectando a tu experiencia de lectura. Puedes consultar aquí los términos y condiciones de la suscripción digital.
Sobre la firma

Archivado En
Últimas noticias
Un petrolero perseguido por Estados Unidos en el Caribe pintó una bandera rusa en un intento de escape
La Ley Silla en Ciudad de México y Estado de México: un derecho que avanza de forma desigual
Mikel Arteta detiene la escalada de Unai Emery en la Premier
El Valencia Basket se pone líder de la Euroliga y el Mónaco castiga al Barcelona
Lo más visto
- La Audiencia Nacional avala la decisión de Robles de retirar el nombre de Franco a una bandera de la Legión
- La auditoría de los pagos del PSOE descarta la financiación irregular, pero cuestiona gastos reembolsados a Ábalos
- Villamanín se instala en el limbo tras la crisis de la lotería y a la espera de acordar qué hacer con el Gordo: de momento, no hay denuncias
- Los ‘tickets’ que Ábalos pasó al PSOE: una comida para nueve en Navidad, “un menú” de 332 euros y cenas en distintos sitios a la misma hora
- El mundo no empeora, mejora: 44 buenas noticias para empezar 2026 con optimismo